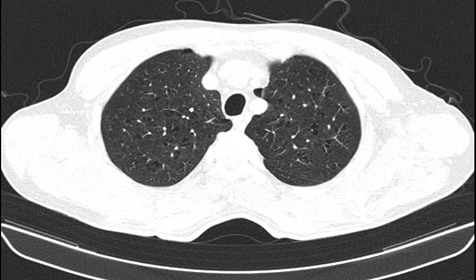

Ca lâm sàng: Chẩn đoán ung thư tuyến giáp di căn não tại Trung tâm Y học hạt nhân và Ung bướu, bệnh viện Bạch Mai
GS. TS Mai Trọng Khoa, BSNT Hữu Phát Huy, BSNT Nguyễn Thu Trang, PGS. TS Phạm Cẩm Phương, PGS.TS. Phạm Văn Thái,
Trung tâm Y học hạt nhân và Ung bướu, Bệnh viện Bạch Mai
Ung thư tuyến giáp (UTTG) là loại ung thư phổ biến nhất trong các ung thư của hệ thống tuyến nội tiết, với tỷ lệ mắc có xu hướng gia tăng trong những năm gần đây. Theo GLOBOCAN 2022, UTTG đứng hàng thứ 7 về số ca ung thư mắc mới và đứng hàng thứ 24 về số ca tử vong trong các loại ung thư. Điều trị UTTG hiện nay chủ yếu là điều trị phối hợp đa mô thức, trong đó phẫu thuật cắt tuyến giáp đóng vai trò nền tảng, tiếp theo là điều trị hormon tuyến giáp ở nhóm nguy cơ thấp hoặc iod phóng xạ I-131 ở nhóm nguy cơ cao kết hợp ức chế TSH.
Ung thư tuyến giáp thể nhú thường có tiên lượng tốt và tiến triển chậm, chủ yếu di căn theo đường bạch huyết vùng cổ. Di căn xa ít gặp, thường gặp nhất là phổi và xương. Di căn não từ ung thư tuyến giáp thể nhú là một dạng hiếm gặp, với tỷ lệ được báo cáo khoảng 0,15% đến 1,3% trong các nghiên cứu y văn gần đây. Tuy nhiên, khi di căn não xảy ra, thường liên quan đến bệnh lan rộng và tiên lượng rất xấu, với thời gian sống trung vị sau chẩn đoán di căn não chỉ khoảng 9–18 tháng trong các phân tích tổng hợp dữ liệu lớn nhất hiện có.
Sau đây, chúng tôi xin giới thiệu một ca lâm sàng ung thư biểu mô tuyến giáp thể nhú có di căn não, nhằm góp phần làm rõ đặc điểm lâm sàng, chẩn đoán và hướng tiếp cận điều trị của tình trạng hiếm gặp nhưng có ý nghĩa tiên lượng nặng nề này.
Họ và tên: V.V.S; Giới: Nam; Tuổi: 60
Lí do vào viện: Đau đầu nhiều
Tiền sử: Khỏe mạnh
Gia đình: chưa có ai mắc bệnh ung thư trước đó
Bệnh sử:
Theo lời bệnh nhân kể, cách ngày vào viện khoảng 5 ngày nay bệnh nhân xuất hiện đau đầu âm ỉ kèm yếu hơn 1/2 người phải, đi khám tại bệnh viện Bạch Mai chụp MRI sọ não phát hiện nhu mô não thùy đỉnh – chẩm trái có các ổ tổn thương ngấm thuốc sau tiêm, phù não rộng xung quanh, ổ lớn nhất ở thùy đỉnh trái kích thước 32x20mm, nhập trung tâm Y học Hạt nhân và Ung Bướu khám đánh giá.
Khám lúc vào viện
Bệnh nhân tỉnh, tiếp xúc tốt.
Thể trạng trung bình, PS = 0.
Mạch: 88 l/p, Huyết áp: 120/80 mmHg, Nhiệt độ: 37 độ C.
Da niêm mạc hồng.
Tuyến giáp không to.
Không phù, không xuất huyết dưới da.
Hạch ngoại vi: không sờ thấy.
Đau đầu nhiều .
Chi trên phải: yếu mức 3–4/5 (có thể nâng cánh tay nhưng yếu khi chống lực).
Chi dưới phải: yếu mức 3–4/5 (đi lại bình thường nhưng khó đi nhanh).
Tim đều, T1 T2 rõ, không phát hiện tiếng bất thường.
Phổi thông khí được, không rales.
Bụng mềm không chướng, gan lách không sờ thấy.
Các cơ quan bộ phận khác: Chưa phát hiện bất thường.
– Cận lâm sàng:
Công thức máu:
| Kết quả | Đơn vị | Giá trị bình thường | |
| Hồng cầu | 4.1 | T/l | 4.37 – 5.69 |
| Hemoglobin | 130 | g/L | 136 – 175
|
| Bạch cầu | 10.84
|
G/L | 4.0 – 10.0
|
| Bạch cầu đa nhân trung tính | 7.99
|
G/L | 1.8 – 7.5
|
| Tiểu cầu | 359
|
G/L | 150 – 400
|
→ Các chỉ số máu của bệnh nhân trong giới hạn điều trị.
Sinh hóa máu:
| Kết quả | Đơn vị | Giá trị bình thường | |
| Creatinin | 69 | µmol/L
|
59 – 104
|
| AST (GOT) | 18
|
U/L
|
<50
|
| ALT(GPT) | 20
|
U/L | <50
|
| Glucose | 11.1
|
Mmol/l | 4.1-5.9 |
| Mức lọc cầu thận ước tính | 98 | mL/phút/
1.73 m2 |
|
| Miễn dịch | |||
| Định lượng CEA (Carcino Embryonic
Antigen)
|
4.03
|
ng/mL
|
Không hút thuốc:
<= 5.0 Đang hút thuốc: <=6.5
|
| Định lượng Cyfra 21-1
|
4.25
|
ng/mL
|
<= 2.37
|
– Siêu âm tuyến giáp: phát hiện hình ảnh eo tuyến giáp lệch trái có nhân hỗn hợp âm kích thước 10x4mm.

– Cộng hưởng từ sọ não:Nhu mô não thùy đỉnh – chẩm trái có các ổ tổn thương tín hiệu không đều, có phần hạn chế khuếch tán, ngấm thuốc sau tiêm, phù não rộng xung quanh, gây hiệu ứng khối đè ép não thất bên bên trái, đẩy đường giữa sang phải 7mm, có ổ ở thùy chẩm trái chảy máu giảm trên T2*, ổ lớn nhất ở thùy đỉnh trái kích thước 32x20mm.
 Hình ảnh các ổ tổn thương não thùy đỉnh – chẩm trái( hình mũi tên đỏ), kèm phù não rộng xung quanh.
Hình ảnh các ổ tổn thương não thùy đỉnh – chẩm trái( hình mũi tên đỏ), kèm phù não rộng xung quanh.
– Chụp Cắt lớp vi tính lồng ngực: Hình ảnh nốt đặc thùy trên phổi trái và thùy giữa phổi phải. Nốt vôi hóa thùy dưới phổi phải. Chưa phát hiện tổn thương ác tính
Phim chụp cắt lớp vi tính lồng ngực
Phim chụp cắt lớp vi tính lồng ngực
– Chụp CT ổ bụng: Nốt vôi hóa gan phải đường kính 5mm, gan có vài nang, đường kính lớn nhất 9mm.
 Hình ảnh nang nhỏ gan và nốt vôi hóa gan phải( vòng tròn màu xanh).
Hình ảnh nang nhỏ gan và nốt vôi hóa gan phải( vòng tròn màu xanh).
– Chụp Xạ hình xương: Chưa phát hiện thấy tổn thương xương trên hình ảnh xạ hình xương toàn thân
 Phim chụp Xạ hình xương toàn thân của bệnh nhân
Phim chụp Xạ hình xương toàn thân của bệnh nhân
– Nội soi tiêu hóa:Viêm dạ dày- viêm hành tá tràng.
 Hình ảnh nội soi thực quản dạ dày- Hành tá tràng
Hình ảnh nội soi thực quản dạ dày- Hành tá tràng
– Bệnh nhân được tiến hành chụp PET/CT toàn thân:
+ Hình ảnh 2 khối tổn thương ở nhu mô não thùy đỉnh – chẩm trái, kích thước lần lượt là 19x38mm và 23x48mm, tăng hấp thu FDG (SUVmax: 22,4); phù não rộng xung quanh, đè đẩy đường giữa sang phải 8mm.
+ Hình ảnh nhân giảm tỷ trọng ở thùy trái tuyến giáp kích thước 9x11mm, tăng hấp thu FDG (SUVmax: 12,6).
 Hình ảnh 2 khối tổn thương ở nhu mô não thùy đỉnh – chẩm trái và hình ảnh nhân giảm tỷ trọng ở thùy trái tuyến giáp( mũi tên màu đỏ)
Hình ảnh 2 khối tổn thương ở nhu mô não thùy đỉnh – chẩm trái và hình ảnh nhân giảm tỷ trọng ở thùy trái tuyến giáp( mũi tên màu đỏ)
– Bệnh nhân được tiến hành chọc tế bào học eo tuyến giáp lệch trái dưới hướng dẫn của siêu âm:
Kết quả:Nghi ngờ ung thư biểu mô tuyến giáp thể nhú.
 Kết quả tế bào học eo tuyến giáp của bệnh nhân sau khi thực hiện thủ thuật
Kết quả tế bào học eo tuyến giáp của bệnh nhân sau khi thực hiện thủ thuật
– Chẩn đoán xác định: Theo dõi ung thư tuyến giáp thể nhú cT1bN0M1 di căn não giai đoạn IV.
– Điều trị: Bệnh nhân đã được hội chẩn hội đồng chuyên môn đưa ra hướng điều trị bao gồm:
1.Điều trị tổn thương di căn não
– Giảm phù não: Dexamethasone liều khởi đầu 4-16 mg/ngày.
– Điều trị đặc hiệu:
– Xạ phẫu định vị (SRS/Gamma Knife): Lựa chọn hàng đầu cho ổ di căn kích thước <3 cm, số lượng ít (2-4 ổ).
2 . Điều trị khối U nguyên phát tuyến giáp.
– Phẫu thuật: Cắt toàn bộ tuyến giáp + nạo hạch cổ trung tâm (xác định chẩn đoán)
– Điều trị I-131.
Bàn luận:
Trong ca lâm sàng này, bệnh nhân nhập viện vì các triệu chứng thần kinh khu trú bao gồm đau đầu và yếu nửa người phải, là biểu hiện điển hình của tổn thương choán chỗ nội sọ, trong khi hoàn toàn không có triệu chứng gợi ý bệnh lý tuyến giáp. Khám lâm sàng không ghi nhận tuyến giáp to hay hạch cổ, và tổn thương tuyến giáp trên hình ảnh học chỉ có kích thước nhỏ. Điều này cho thấy di căn não có thể là biểu hiện đầu tiên của ung thư tuyến giáp thể nhú, ngay cả khi u nguyên phát còn rất nhỏ, một tình huống hiếm gặp nhưng đã được ghi nhận rải rác trong các báo cáo ca bệnh trước đây.
Hình ảnh cộng hưởng từ sọ não cho thấy nhiều ổ tổn thương thùy đỉnh – chẩm trái, ngấm thuốc mạnh sau tiêm, kèm phù não rộng và hiệu ứng khối rõ rệt, có đẩy lệch đường giữa và ổ xuất huyết trong tổn thương. Đây là những đặc điểm hình ảnh thường gặp của di căn não. Sự hiện diện của xuất huyết trong ổ di căn càng củng cố khả năng nguồn gốc từ ung thư tuyến giáp, melanoma hoặc ung thư thận, trong đó ung thư tuyến giáp thể nhú cần được cân nhắc ngay cả khi tổn thương nguyên phát không rõ ràng.
PET/CT FDG toàn thân đóng vai trò then chốt trong chẩn đoán của ca bệnh này khi vừa khẳng định tính chất ác tính của các tổn thương não thông qua mức tăng hấp thu FDG cao, vừa phát hiện được ổ tổn thương tuyến giáp kích thước nhỏ nhưng có chuyển hóa tăng rõ, đồng thời loại trừ các ổ di căn xa khác. Điều này nhấn mạnh giá trị của PET/CT trong tiếp cận các trường hợp di căn não chưa rõ nguyên phát, đặc biệt khi các phương tiện chẩn đoán hình ảnh thông thường không phát hiện được tổn thương rõ ràng tại tuyến giáp.
Kết quả chọc hút tế bào kim nhỏ dưới hướng dẫn siêu âm cho thấy hình ảnh nghi ngờ ung thư biểu mô tuyến giáp thể nhú, phù hợp với dữ liệu lâm sàng và hình ảnh học. Mặc dù khối u nguyên phát có kích thước nhỏ và không ghi nhận hạch cổ, sự hiện diện của di căn não đã xếp bệnh nhân vào giai đoạn IV theo phân loại TNM, phản ánh vai trò quyết định của di căn xa trong tiên lượng bệnh, vượt xa ý nghĩa của kích thước u nguyên phát đơn thuần.
Việc điều trị ung thư tuyến giáp thể nhú di căn não hiện nay chưa có phác đồ chuẩn thống nhất do tính chất hiếm gặp của bệnh. Các chiến lược điều trị thường mang tính cá thể hóa, bao gồm phẫu thuật cắt bỏ tổn thương não khi có chỉ định, xạ trị não toàn bộ hoặc xạ phẫu định vị nhằm kiểm soát tổn thương tại chỗ và triệu chứng thần kinh, kết hợp với cắt tuyến giáp toàn bộ và điều trị iod phóng xạ nếu tổn thương còn bắt iod. Trong các trường hợp bệnh tiến triển hoặc kháng iod, điều trị toàn thân bằng thuốc nhắm trúng đích có thể được cân nhắc. Tuy nhiên, mặc dù áp dụng điều trị đa mô thức, tiên lượng của bệnh nhân ung thư tuyến giáp thể nhú có di căn não vẫn còn hạn chế.
Ca lâm sàng này cho thấy ung thư tuyến giáp thể nhú, dù thường được xem là bệnh lý có tiên lượng tốt, vẫn có thể biểu hiện bằng di căn não ngay từ thời điểm chẩn đoán ban đầu. Do đó, ở những bệnh nhân có di căn não chưa rõ nguyên phát, cần nghĩ đến nguồn gốc tuyến giáp ngay cả khi tổn thương nguyên phát nhỏ và không có biểu hiện lâm sàng rõ ràng, nhằm tránh chậm trễ trong chẩn đoán và tối ưu hóa chiến lược điều trị.
Tài liệu tham khảo
- International Agency for Research on Cancer. (2022). Thyroid cancer fact sheet – Estimated incidence, mortality and prevalence worldwide in 2022 (GLOBOCAN 2022). Global Cancer Observatory.
- R Jyothirmayi, J Edison, P P Nayar, M K Nair, B Rajan, Brain metastases from papillary carcinoma thyroid, British Journal of Radiology, Volume 68, Issue 811, 1 July 1995, Pages 767–769, https://doi.org/10.1259/0007-1285-68-811-767.
- National Comprehensive Cancer Network. (2025). NCCN Clinical Practice Guidelines in Oncology (NCCN Guidelines®): Thyroid carcinoma (Version 1.2025). NCCN.





